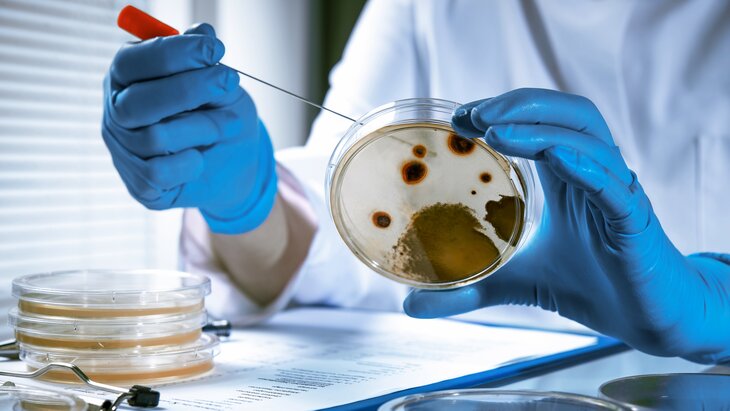

30 января 2023, 15:51
ПолитикаВ Минобороны РФ заявили о причастности США к появлению COVID-19
Фото: depositphotos/alexraths
Появление коронавирусной пандемии связано с проведением США учений в Нью-Йорке в 2019 году. Об этом заявил начальник войск радиационной, химической и биологической защиты (РХБЗ) ВС РФ Игорь Кириллов.
"Развитие пандемии COVID-19 именно по этому сценарию ставит вопросы о ее преднамеренном характере, причастности США к данному инциденту, а также истинных целях американских биопрограмм, направленных на усиление свойств опасных патогенов", – цитирует его РИА Новости.
Кириллов подчеркнул, что 18 октября 2019 года, за два месяца до первой официальной информации о возникновении новой инфекции в КНР, Университет Джона Хопкинса совместно с Фондом Билла и Мелинды Гейтс организовали в Нью-Йорке учения Event 201.
По мнению генерала, во время данных мероприятий американцы отработали действия в условиях эпидемии. По сценарию вирус перенесла летучая мышь человеку через организм свиньи.
Кириллов отметил, что американская компания EcoHealth Alliance с 2015 года занималась поиском новых штаммов COVID-19 и механизмов их передачи от животных к человеку. Организация играла ключевую роль в реализации данных проектов. Генерал поделился, что российская сторона изучила документы управления по снижению угрозы Минобороны США (DITRA). Выяснилось, что специалисты EcoHealth Alliance изучили порядка 2,5 тысячи особей.
Впоследствии сотрудникам компании рекомендовали при появлении инфекции с усиленными в 10 раз свойствами передачи и патогенности сразу прекратить все исследования и сообщить об этом сотрудникам Национального института аллергологии и инфекционных заболеваний Штатов.
Кириллов уверен, что американские правоохранители знали о подкупе представителей СМИ и соцсетей во время освещения причин появления COVID-19. РФ ранее представила документы военно-биологических программ Пентагона на Украине, вызвав общественный резонанс. Ряд экспериментов был проведен в том числе и на территории США.
Между тем американский сенат по здравоохранению, образованию, труду и пенсиям заявил, что коронавирусная пандемия могла возникнуть из-за ЧП, связанного с исследованием. Однако новые данные, которые в будущем представят общественности, могут изменить подобную оценку.
Кроме того, ученые США назвали не вызывающей доверия теорию о естественном природно-очаговом происхождении вируса.
В РФ не будут вводить ограничения из-за выявления варианта коронавируса "Кракен"








Сергей Собянин: Москва входит в число мировых центров разработки видеоигр























